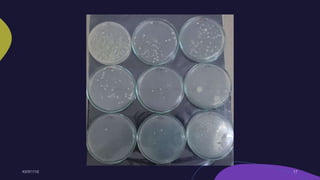
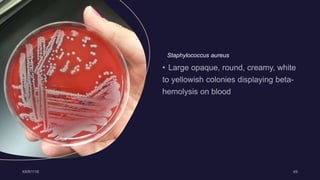
Staphylococcus aureus

This document describes techniques for isolating pure cultures of microorganisms, including serial dilution, spread plating, streak plating, and pour plating. Serial dilution involves sequentially diluting a sample to reduce the concentration of microbes and allow discrete colonies to form. Spread plating involves spreading diluted samples evenly across agar plates, streak plating uses inoculation loops to streak samples in patterns to further dilute and separate microbes, and pour plating involves mixing diluted samples into molten agar before pouring into plates. These techniques are important for isolating pure cultures needed to accurately identify and study microbes.

![A micromanipulator is a device which is used to physically interact with a sample under a microscope, where
a level of precision of movement is necessary that cannot be achieved by the unaided human hand.[1] It may
typically consist of an input joystick, a mechanism for reducing the range of movement and an output section
with the means of holding a microtool to hold, inject, cut or otherwise manipulate the object as required. The
mechanism for reducing the movement usually requires the movement to be free of backlash. This is achieved
by the use of kinematic constraints to allow each part of the mechanism to move only in one or more
chosen degrees of freedom, which achieves a high precision and repeatability of movement, usually at the
expense of some absolute accuracy.
MICROMANIPULATOR METHOD](https://image.slidesharecdn.com/pureculturetechniques-210623082653/85/Pure-culture-techniques-35-320.jpg)